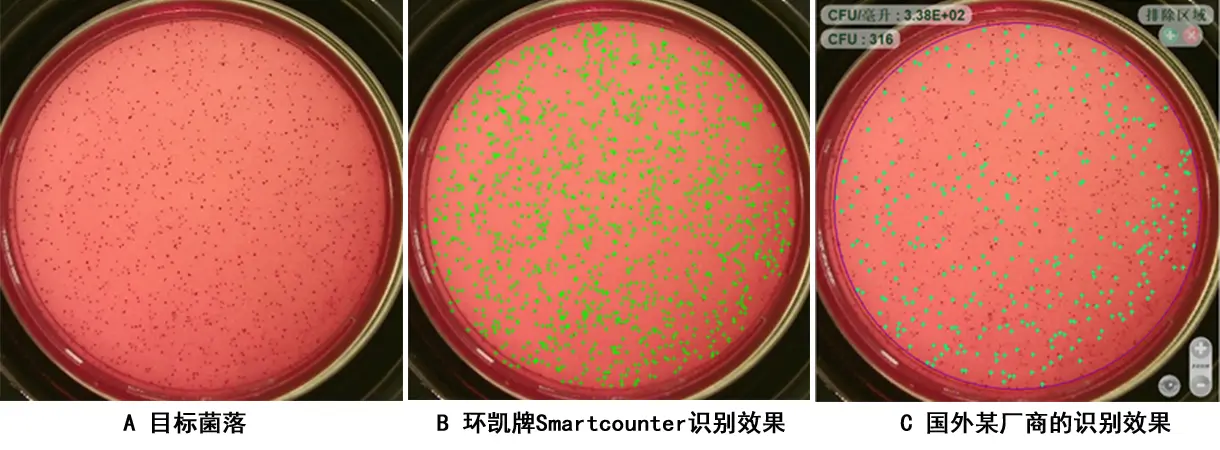

环凯牌Smartcounter全自动菌落计数器 在实际应用中的表现
发布时间:2021-07-27 浏览次数:4774
Smartcounter全自动菌落计数器由先进的图像采集技术,结合专业开发的图像处理软件构成。仪器性能稳定、功能强大、使用操作界面简单直观。具有对微生物菌落进行统计、分析、测量、数据存贮和管理、分析结果报表打印等全系列先进的功能,是微生物实验室的理想设备。
自初代Smartcounter全自动菌落计数器问世以来,该产品已历经几万次的应用测试。我们不断根据产品在实际使用情况下所遇到的问题迭代优化,目前该产品在稳定性,识别精度和识别速度等各项指标上都已达到领先水平。以下将展示我们在走访客户过程中,针对“困难”菌落难以识别的客户“痛点”,环凯牌Smartcounter全自动菌落计数器在这些困难菌落上的表现。同时,我们也给出了国外某大厂同类产品在这些困难菌落上的表现情况。
一:直径差异大的菌落
菌落来源:广东某微生物研究所

二:密集+粘连菌落
菌落来源:广东某生物科技有限公司

三:密集+粘连+明暗差异大+直径差异大+笔迹干扰菌落
菌落来源:广东某生物科技有限公司

四:高度粘连+明暗差异大+笔迹干扰菌落
菌落来源:某生物公司

五:密集+小尺寸+纸片培养基菌落
菌落来源:广东某微生物科技有限公司

六:密集(CFU>1000)+微小尺寸菌落
菌落来源:某乳业
七:密集+形状不规则+对比度小菌落
菌落来源:某生物科技有限公司

八:密集+直径差异大+对比度小菌落
菌落来源:某生物科技有限公司

九:3M纸片+小尺寸菌落
菌落来源:某生物公司

十:白色小尺寸+格栅膜+黑色背景菌落
菌落来源:某药业

十一:密集(CFU>1000)+白色小尺寸+格栅膜+黑色背景菌落
菌落来源:某药业

十二:白色背景+格栅膜+白色菌落
菌落来源:某药业

十三:密集(CFU>1500)+小尺寸+白色背景+格栅膜+白色菌落
菌落来源:某药业

十四:超密集(CFU>2500)+微小尺寸+对比度小+笔迹干扰菌落
菌落来源:深圳某大学

十五:抑菌圈识别分析功
能样本来源:某微生物研究所
环凯牌Smartcounter全自动菌落计数器除了具有菌落计数功能之外还具有强大的抑菌圈分析功能,该功能可以测量抑菌圈直径,抑菌带宽度等。

后记
环凯牌Smartcounter全自动菌落计数器在实际复杂的菌落识别上仍能保持优异的性能。要做到这一点,除了有优异的硬件保证采样精度之外,更需要优秀的识别算法相配合。广东环凯生物科技有限公司设计开发了用于平皿菌落识别的算法模型,该模型确保了设备能达到人眼识别的水平(人眼可识别,则设备亦可识别)。
设备正常状态下识别精度可达0.2mm,通过软件界面修改参数可进一步提高识别精度。在CFU<100时,误差不超过1%。100<CFU<300时,误差不超过2%。当cfu>300且肉眼可见时,误差不超过6%。
环凯牌Smartcounter全自动菌落计数器软件界面简洁,使用简单,在大多数情况下,您只需点击一个“确认”按键即可完成复杂菌落的识别。对于复杂的菌落,您也只需做简单的操作,调整几个参数即可完成识别。
